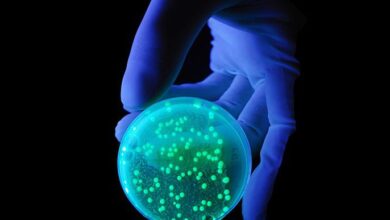

نتیجه جستجو برای :چای سبز
- اخبار

کاهش خطر زوال عقل با تغذیه سالم
تیمی از پژوهشگران اسپانیای در مطالعات جدید خود دریافتند رژیم غذایی سرشار از محصولات گیاهی خطر ابتلا به اختلالات شناختی…
- اخبار

باکتریهای پروبیوتیک علایم بارداری را کاهش می دهند
مطالعات جدید محققان دانشگاه یوسی دیویس نشان میدهد باکتریهای پروبیوتیک به طور قابل توجهی علایم بارداری مانند تهوع، استفراغ و…
- اخبار

کدام خوراکی ها به کاهش آسیب آلودگی هوا کمک می کند؟
آلودگی هوا چهارمین علت مرگ در دنیا محسوب میشود و بعد از فشار خون بالا، مصرف دخانیات و سوءتغذیه، آلودگی…
- اخبار

زیبایی پوست با گیاهان دارویی
يکی از مهمترین دلایل توجه به پوست، جدا از تاثیرات آن بر زیبایی، تاثیر آن بر سلامتی کل بدن میباشد.
- اخبار
آنتیبیوتیکهای طبیعی در بدن انسان کشف شد
پژوهشگران "دانشگاه پنسیلوانیا" موفق شدهاند گروه جدیدی از آنتیبیوتیکهای طبیعی را در بدن انسان کشف کنند که میتوان از آنها…
- اخبار

اصفهان پیشتاز در کشت گیاهان دارویی
اصفهان با ۷ هزار و ۵۰۰ هکتار سطح کشت گیاهان دارویی حائز رتبه نخست کشور در این حوزه است.
- اخبار

مصرف خودسرانه آنتی بیوتیک عاملی برای ابتلا به کرونا
به گفته استاد دانشگاه علوم پزشکی تهران ، مصرف خودسرانه آنتی بیوتیک در دوران کرونا باعث می شود ذخایر باکتریایی…
- اخبار

نکات تغذیه ای قبل و بعد از واکسیناسیون کرونا را بدانید
دفتر بهبود تغذیه جامعه معاونت بهداشت وزارت بهداشت، درمان و آموزش پزشکی در گزارشی نکات تغذیه ای که قبل و…
- اخبار

چگونه از کبد محافظت کنیم؟
قسمت عمده سیستم تصفیه بدن به عهده کبد است. عملکرد این عضو به اندازهای حیاتی است که کمترین آسیب به…
- اخبار

نوشیدن قهوه در حفظ سلامت و تقویت عضلات نقش دارد
مطالعات جدید محققان ژاپنی نشان میدهد نوشیدن یک فنجان قهوه در صبح در حفظ سلامت و تقویت عضلات نقش دارد.